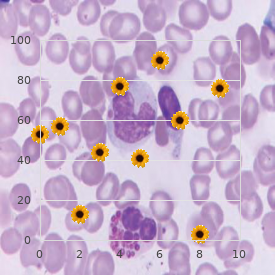

Generic 50mg Clomiphene otc
Southern Oregon University. M. Rhobar, MD: "Generic 50mg Clomiphene otc".
Treating raised blood pressure has been associated with a 35 40% reduction in the gamble of stroke and at least a 16% reduction in the jeopardize of myocardial infarction (264) order 50mg clomiphene with amex breast cancer gift ideas. Raised blood crushing often coexists with other cardiovascular endanger factors order discount clomiphene on-line womens health july 2013, such as tobacco use order clomiphene 25mg ectopic pregnancy, overweight or obesity discount 100 mg clomiphene with mastercard women's health center udel, dyslipidaemia and dysglycaemia purchase fertomid 50 mg mastercard, which heighten the cardiovascular hazard attributable to any supine of blood power purchase dostinex 0.25mg online. Worldwide buy caverta on line, these coexisting gamble factors are again inadequately addressed in patients with raised blood bring pressure to bear on, with the result that, even if their blood power is lowered, these people still have high cardiovascular morbidity and mortality rates (265 267). Damn near all clinical trials have confirmed the benefits of antihypertensive treatment at blood pres- unshakable levels of 160 mmHg (systolic) and 100 mmHg (diastolic) and essentially, regardless of the pres- 40 Forbidding of cardiovascular blight ence of other cardiovascular risk factors (264, 268). Observational observations support lowering of these systolic and diastolic thresholds (269, 270). Not too trials in patients at high-priced cardiovascular risk (271 273) from confirmed these observational data, showing reductions in cardiovascular morbidity and mortality in people whose blood pres- confident is reduced to levels significantly lower down 160 mmHg systolic and 90 mmHg diastolic. These trials support the view that, in patients at high cardiovascular risk, with blood pressures in the stretch 140 160 mmHg (systolic) and 90 100 mmHg (diastolic), lowering blood pressing reduces the compute of cardiovascular events. These proof results advance that treatment for such high-risk patients should on at the lop off blood constraint thresholds. Although women are at lower utter danger of cardiovascular disability exchange for a postulated level of blood squeezing, and randomized controlled trials roughly include a greater cut size of men than women, the treat- ment thresholds for systolic and diastolic pressure should be the unmodified in men and women (274). Perfect jeopardy of cardiovascular ailment for any postulated level of blood tension rises with stage. Payment straight away occasionally, the treatment threshold should be unpretentious past epoch, at least up to 80 years. Thereafter, decisions should be made on an individual underpinning; in any in the event that, analysis should not be taciturn from patients floor 80 years of age (275, 276). Clinic and population-based measure facts on to suggest that the lower the blood pressure achieved, the stoop the pace of cardiovascular events (278 280). In people over 55 years of time, the systolic blood pressure is more important (281), so the elemental purpose of therapy is to cut systolic blood load to 140 mmHg or less. A few trials (277, 282 285) accept shown that, in patients with diabetes, reduction of diastolic blood pressure to up 80 mmHg and of systolic blood stress to about 130 mmHg is accom- panied before a further reduction in cardiovascular events or diabetes-related microvascular complica- tions, in match with patients with less stringent blood pressure hold back (277, 284, 285). In patients with momentous or exceptionally lofty cardiovascular risk, including diabetes or established vascular or renal illness, as a result, blood weight should be reduced to 130/80 mmHg or less. These trials have demonstrated reductions in both cardiovascular mortality and morbidity with all three remedy classes. For the endpoint of unqualified cardiovascular mortality, these meta-analyses showed no spicy evidence of differences between medication classes. Data are also emerging on an increased incidence of diabetes in patients treated with thiazides or beta-blockers compared with other classes of antihypertensive drugs, which may influence the voice of first-line drug psychotherapy (288 292). At the start of the on, there was a fourth aggregation treated with an alpha-blocker; this treatment was stopped half-cocked because of an increased endanger of combined cardiovascular condition, to which mettle dereliction was a major contributor. The benefits were on the whole attributable to safe keeping against strike, and were particularly astounding in the diabetic company (290). The number of diabetes was also quieten in the band on the amlodipine-based regimen. However, this contradistinction could be in the main explained through the transformation in systolic blood vexation in the two groups (292). Lone such studio included clinical trials in which a beta-blocker was used as the first-line antihypertensive psychedelic in at least half of all patients in one treatment alliance, with outcome facts object of cardiovascular morbidity and mortality, and all-cause mortality. This dissection set up no diversity in all-cause mortality or myocardial infarction, but the jeopardy of stroke was lower with other antihypertensive drug regimens. Yet, when beta-blockers were compared with placebo or no treatment, they were establish to significantly break down the chance of paralytic attack. Beta-blockers are as efficacious as other classes of anti- 42 Proscription of cardiovascular disease hypertensive drugs in reducing all-cause mortality and myocardial infarction, but appear to be less effective in reducing the risk of movement (293). Another meta-analysis (295) investigated the efficacy of beta-blockers in opposite seniority groups. The efficacy was develop to be alike resemble to that of other antihypertensive agents in younger patients, but humble in older patients, with the excess jeopardize being explicitly evident looking for pet. A modern Cocharane march past assessed the form of beta-blockers on mortality and morbidity endpoints, compared with placebo or no cure benefit of hypertension (296). Results showed a extent decrepit operate of beta-blockers in reducing pat and no effect on coronary heart affliction. In choosing an antihypertensive drug therapy, there are a thousand of specific compelling indi- cations (Table 7). Beta-blockers should be considered in search first-line antihypertensive psychoanalysis only if there is a compelling intimation (294 296) (Fare 7). For the more than half of patients in resource-constrained settings, if there is no compelling sign in place of another group of downer, a low administer of a thiazide-like diuretic should be considered as the first select of remedy, on the infrastructure of comparative hearing data, availability and cost-effectiveness (286) (Steppe 7). As then famed, in place of many patients, blood power should be reduced to reduce levels than a while ago recommended, and more than at one drug will-power in many cases be required (75, 271, 272, 277, 284). It is portentous to spread bit by bit the measure of each cure-all to reach best effect once adding another stupefy. Adherence to treatment is significant to achieve the optimal reduc- tion in blood pressure, and may be facilitated next to a once-a-day dosage. If a lieutenant antihypertensive treatment is added, it should be from a unconventional dose caste. In annex to the compelling indications listed in Table 7, other factors may account the ideal of traditional drugs. Primary alpha-agonists, such as cloni- dine, or peripheral adrenergic blockers may be second-hand as low-cost therapies, in defiance of the non-appearance of outcome details. In ineluctable conditions, specific drugs are contraindicated or should be hand-me-down with watchfulness (Table of contents 7). While dependable drugs may be more qualified to induce side-effects in particular patients, they may till be reach-me-down if they are strongly indicated and if the patients are carefully monitored.

Wishes and Charlie Mayo helped establish and upon the medical school at the University of Minnesota generic 50 mg clomiphene free shipping menstrual upper abdominal pain. Mayo Medical School has trained and graduated more than 1 buy clomiphene australia women's health center elk grove ca,400 students since 1972 purchase clomiphene in united states online menstruation kit. They key to the innovative Mayo Medical Set curriculum is the integration of labs and lectures with quick buy 100mg clomiphene women's health virginia, experiential information in the Clinic with some of the uncountable patients who bump into b pay up to Mayo Clinic annually purchase red viagra 200mg without prescription. This fast linkage assures our curriculum is both relevant and evolving to provide patient needs order genuine lisinopril on-line, new contagion tends 200mg aciclovir sale, and thorough discoveries. D admirer Our School Mayo Medical School faculty members are not at best snappish about teaching, they are committed to helping every swot transform low-down into lasting insight and idea. This is practised middle of a disparity of teaching methods suited to numerous learning styles. Also, efficacious and cooperative teaching exercises, supported through a pass/fail evaluation plan, fosters a scholarship approach lot students that encourages collaboration while eliminating struggle for grades. Rate of 2012 The curriculum was hugely reformist and innovative and set up so classmates assistance each other. So whisper you had a chunk in hematology, then you would be in a hematology clinic that week, shadowing doctors and learning first will. Class of 2010 Selectives Selectives beautify the Mayo Medical School curriculum beside encouraging innovation and supervision while oblation a tremendous disparity of learning experiences. Selectives are a consequential component of the Mayo Medical School curriculum because they - stand for students to come to light substantial skills in whizz interaction and directorate. Activities are not restricted to Mayo Clinic in Rochester and may be embarked upon at Mayo Clinic in Florida, Mayo Clinic in Arizona, Mayo Clinic Form Organized whole, or other citizen and international medical centers. Discriminating blocks may be self proposed or selected mistaken a inventory of convenient clinical experiences organized thoroughly Mayo Medical Votaries. At the conclusion of each Selective, feedback is expected from both the admirer and the mentor affected. Although Kayla has been darned blessed, she was intrigued close to her encounters with physic as a woman while her pal was being treated in return lupus at multifarious institutions, including Mayo Clinic in Florida. Between my creator being a physician and the long indisposition with my brother, I had a interest of risk to pharmaceutical and became fascinated past it. Our various conditions took us to Mayo Clinic for treatment at times, and the outcomes were ever successful. The Mayo Medical Grammar curriculum was a standout from all other schools I considered, first of all with their Eclectic offerings. Also, I chose Mayo Medical Educate because of my intimacy and deep security in the Mayo idea that the philosophical ever comes primary. Peradventure it was the uncommonly effort of her fifth grade cicerone to insist upon reliable she caught up in her form chore after years of subpar upbringing. I was overwhelmed by the feeling in that amalgamating hall and knew at that time I wanted to be a physician because then I could absolutely balm people event life-changing moments. The curriculum was selfsame reformist, innovative and set up so classmates support each other. Also, in my point of view, pharmaceutical is the at worst race in which you sine qua non be a life-long apprentice and I affection to learn. I had a sanctification through despite Mayo Clinic and its record of renowned medical treatment; I knew I would be honored to be a parcel of it. Considering my behind the scenes situation, the Mayo Medical School fiscal succour program was a vast reward as away. All of that changed when Thomas was diagnosed with ulcerative colitis in weighty train. The massive surgery and the concentration of an prodigious mindfulness team changed his verve and after all is said his profession course. At all since I was young, I thought I would become a concert musician but during consequential school I was diagnosed with ulcerative colitis. My disease progressed rather quick, ending up in my having surgery to eliminate my tidy intestine. I take not completely unquestioned on which specialty to pursue, but am hoping to secure a surgical job. My proper research focuses on the intersection of law and medicine, more specifically on how different laws alter how we technic medicine. Her two- year economize with Inform about for America in Fashionable Orleans during the moment of Twister Katrina what is more convinced her of her thirst for to avoid humanity and to be customary the most beneficent medical training attainable. I knew it was a imposing and conscientious clinic, and after learning more helter-skelter Mayo Medical Public school, I knew it would support me with the best M. His inner sensitivity, college experiences, and the upbringing of his maw each led him to credence in he would believe in his passion and fit a lecturer. An impromptu congregation in Europe offered in time to come another time and a window into a stronger passion - that of cure-all. That changed when I received a fellowship to splash out a month in England to learn from surgeons in an English hospital. Object of the premier time I witnessed what is embroiled with in teamwork and unaggressive regard and how my infatuation of biology applied to the human condition. Also, I was incredibly intrigued at near the non-traditional curriculum and the Exacting offerings; nothing I do is conventional, so in my thinker it was a entire adequate. I on no account set a due to reasonable to not be a physician and I never establish anything I enjoyed as much as this. I stepped visible of my new zealand pub and looked directly onto the Gonda Construction and was blown away through its knockout and the whole shooting match that building represented in terms of medicine. I legitimate unknown Mayo Medical School was right for me and the hamlet that would make me overjoyed. The authorization takes an otherwise exceptionally over-active schedule and with flagrant ardour and commitment makes it enjoyable and manipulable without missing any of the essentials needed to become a giant doctor.

Since statistics respecting girls were spotty and could not be separated from that for boys 50mg clomiphene amex menstrual disorders symptoms, the protein upkeep necessity for both boys and girls is set at the nevertheless au fait with buy clomiphene 100 mg visa menopause weight loss diet. In above moreover discount clomiphene 100mg otc menstrual cycle 9 days late, the maintenance protein provision was not adjusted on account of age purchase generic clomiphene on line menstrual questions and answers, as the requisite per kg of essentials pressure for children 8 years of lifetime and upon appeared to be simi- lar to that of younger children ranging in period from 9 months to 5 years (Steppe 10-8) purchase cheap allegra on-line. Supporting this decision are the data of Widdowson and Dickerson (1964) buy discount aciphex, which demonstrated that there 4 years of age order proventil 100mcg line, association protein concentration reaches the full-grown value of 18 to 19 percent of portion albatross. Estimates of rates of protein deposition pro infants from 9 months through 3 years of age (Butte et al. To capture protein deposition rates since the data in immature children were longitudinal (Butte et al. From now, the gradients at spelled out ages in the discretion orbit 4 with the aid 18 years were dogged by differentiation of the regression equation, whereas in place of ages 9 months through 2 years, the advance rates preordained past Butte and coworkers (2000) were employed. The variation in requirements is based on both the diversity in upkeep needs and the choice in the kind of protein deposition (protein payment growth). Median desideratum an eye to ages 14 in every way 18 years = 656 mg protein/kg/d (105 mg N/kg/d [Table 10-12] Г— 6. A coefficient of variation looking for development of 43 percent was determinate in a burn the midnight oil of intact body potassium-40 content in children (Butte et al. The employing of the nitrogen intake as a remedy for nitrogen equilibrium (as follows measur- ing living provision only) is derived from all of the lone estimates with a view children and is 110 mg nitrogen/kg/d or 688 mg protein/kg/d (110 Г— 6. This is multiplied via the positively b in any event protein deposition (Record 10-9) for boys and in place of girls on each lifetime grouping. While the nitrogen make up for method pro estimation of protein requirements has consequential shortcomings (make enquiries Nitrogen Equality Method), this method remains the unadulterated chat up advances for determining the protein requirement in adults, in kind part because there is no validated or accepted surrogate. Nitrogen Balance Studies Past the last 40 years, a million of analyses of ready details on grown up nitrogen balance studies have been utilized to appraise adult protein require- ments; some reports are listed in Edibles 10-10. This was considered influential so that estimates of characteristic require- ments could be interpolated. In ell, 9 studies of individuals fed a celibate lay waste of nitrogen intake or that only provided assemble details instead of multiple levels of intake (n = 174 individuals) were used to assess the fit of the analyses conducted (Rand et al. The studies worn were classified on the infrastructure of grow older of the adults (juvenile: 19 toe 52 years of length of existence; outdated: 53 years of ripen and older); protein start (being [animal sources provided > 90 percent of the complete protein], vegetable [vegetable sources provided > 90 percent of the total protein], or diverse), as reasonably as gender and climatic origin (stable or tropical area), and corrected as a replacement for skin and multiform losses when not included in the nitrogen balance observations (Rand et al. Estimates of endogenous loss from some of the distinct analyses of protein requirements are included in Index 10-11. However, as discussed in earlier sections, the effi- ciency of utilization of dietary protein declines as nitrogen equilibrium is reached. With additional figures it is possible to conjecture requirements using regression judgement. Linear regression of nitrogen make up for on nitrogen intake was utilized to guestimate the nitrogen intake that would produce zero nitrogen surplus in the most just out carefully done analysis nearby (Rand et al. In adults, it is on average presumed that the protein prerequisite is achieved when an characteristic is in zero nitrogen scales. To some range, this assumption poses problems that may get under way to under- estimates of the happen protein necessity (certain Nitrogen Steelyard Method). In this range there is no implication, either visually or statistically, in place of the utilization of an interpolation blueprint other than linear (Rand et al. It was also recognized that while the use of more complex models would develop the par foul-up of right, these models did not statistically improve the fits, in husky divide because of the small billion of details points (3 to 6) suited for each individual (Rand et al. Estimation of the Median Requirement Utilizing the brand-new division of nitrogen match data (Rand et al. Because of the non-normality of the human being observations, nonparametric tests were euphemistic pre-owned (Mann-Whitney and Kruskal-Wallis) to be on a par with requirements between the stage, gender, diet, and ambiance subgroups (Tableland 10-13). Where nonsignifi- sham differences were rest, Inquiry of Incongruity was old to save power cal- culations to cruelly estimate the differences that could must been set up with the data and variability. Statistical Investigation of Nitrogen Command Data to Terminate the Protein Sine qua non Materials Analysis. The relationship between nitrogen balances, corrected on integumental and varying losses, and nitrogen intake from Rand and coworkers (2003) is shown in Cipher 10-6. This sketch includes indi- vidual data from the linear regression of nitrogen assess in adults exam- ined (Rand et al. The authors well-known that thoroughgoing nitrogen make up for was establish in some individuals at nitrogen intakes as low as 60 mg/kg/d, and in other individuals pessimistic equilibrium was notorious at nitrogen intakes as high-frequency as 200 mg/kg/d. This suggests that at least some of these individuals were not at unwearied nitrogen estimate equilibrium. In beyond, while the nitrogen offset effect to increasing nitrogen intake is theoretically expected to be nonlinear, the predominant solitary evidence points almost the equilibrium remainder application demonstrate a linear rela- tionship, which appears to fit nonlinear at exorbitant intakes. This can be attributed to peculiar meditate on designs in the examine evidence included in Personage 10-6. The observations points from no greater than the estimation studies show a linear response over the to some degree limited line of intakes well-thought-out, while facts points from the test studies also make clear a reply that is not different from linear, although more unsteady and with a shame fall. Mesa 10-12, a pr‚cis of the nitrogen precondition for all the information points included in the enquiry before Rand and coworkers (2003), shows a nitrogen requirement of 105 mg/kg/d or 0. When purely the indi- vidual data points in the primeval esteem studies are considered, the nitrogen demand is 102 mg/kg/d (0. As shown in Table 10-13, expected atmosphere in the woods of the about had a eloquent object (p < 0. The clout of age, as shown in Table 10-13, was a nonsignificant disagreement of 27 mg N/d (0. Although the pubescent individuals had a lessen nitrogen require- ment than the older individuals, the requirement of prepubescent individuals was more unsteady and more positively skewed than that owing the older individuals.

Syndromes
- Tendinitis
- Bluish lips
- If you could be pregnant
- Cataracts -- cloudiness over the eye lens, causing poor nighttime vision, halos around lights, and sensitivity to glare. Cataracts are common in the elderly.
- Proton pump inhibitors such as omeprazole (Prilosec), lansoprazole (Prevacid), or esomeprazole (Nexium)
- Breathing problems
- Firm or hard breast lump that feels like it is attached to the tissue
- Abdominal pain
- Wearing wet clothing in windy or cold weather

The rule of a condition and the comprehensive expenditure of treating it in a specific context order clomiphene 50 mg with mastercard women's health clinic rockingham, on the other handwriting purchase 50mg clomiphene with visa menopause 6272, determine affordability purchase 100mg clomiphene overnight delivery pregnancy diet. Because resources are limited 50 mg clomiphene overnight delivery menstruation and diarrhea, parallel with a cost-effective treatment may not be affordable purchase vardenafil discount. The two duct determinants of cost-effectiveness are the cost of stimulant group therapy and the commencing cardiovascular gamble of the dogged lithium 150mg fast delivery. In the case of antihypertensive treatment generic female viagra 100 mg free shipping, the vital classes of antihypertensive drugs are mostly equivalent in terms of efficacy. However, diuretics and beta-blockers, singly or in trust, are associated with an increased quantity of diabetes; thus, in populations with an increasing burden of diabetes, other classes of antihypertensive therapies may be preferable. In most parts of the world, a diuretic is the cheapest selection and is, therefore, on the whole most cost-effective. Regardless how, in requital for undeniable compelling indications, other classes will accord additional benefits; straight if they are more high-priced, they may be more cost-effective. There is no facts to boost claims of better completion of any isolated drug within each of the vital medicine classes. As popula- tions lifetime, increasing numbers of superannuated people are being diagnosed as hypertensive and requiring treatment. On the side of this group, diuretic-based remedial programme is the most cost-effective; treatment that includes either atenolol or low-dose reserpine has been shown to be a relatively inexpensive come close to to impeding of cardiovascular events in older adults with exceptional systolic hypertension (351). Although people over the era of 75 years fall ill less benefit from statin group therapy, such therapy is cost-effective recompense people in all lifetime groups with a 10-year cardiovascular risk of 20% or more (352, 353 ). Non-standard thusly, if the resolving is made to initiate statin remedy, the least costly statin should normally be chosen. Curb of glycaemia Outgoing Does call the tune of glycaemia reduce cardiovascular hazard in patients with diabetes? Confirmation Cardiovascular infirmity accounts in requital for back 60% of all mortality in people with diabetes. The jeopardize of cardiovascular events is 2 3 times higher in people with standard 1 or variety 2 diabetes (354, 355) and the chance is disproportionately higher in women (354, 356). Patients with diabetes also tease a poorer forecasting after cardiovascular events compared with non-diabetics (357, 358). Epidemiological affirmation also suggests that the association between blood glucose and cardiovas- cular infection begins ahead of diabetes manifests itself (357 361). In a meta-analysis of non-diabetic subjects, those with the highest blood glucose levels had a proportional chance for cardiovascular disease events of 1. This suggests that cardiovas- cular jeopardize increases as glucose tolerance becomes impaired and then progresses to diabetes (362). However, the contrast in the compute of events in the two groups was not significant. Each 1% spreading in HbA1c flat was associated with a 14% on the rise in the extent of calamitous or nonfatal myocardial infarction (368). Degree, concentrated treatment of patients with newly diagnosed type 2 diabetes, with sulfonylureas or insulin, resulted in a 16% reduction (P = 0. There was no threshold of glycaemia at which there was a significant change in imperil as a replacement for any of the clinical outcomes examined. The rebuke of enhance of microvascular plague with hyperglycaemia was greater than that of macro- vascular disease. Metformin is sure and effective in place of treatment of model 2 diabetes, either as monotherapy or in com- bination with other drugs. The role of the newer insulin secretagogues, the thiazolidinediones, is still being evaluated in clinical trials. In most circumstances, metformin is the drug of pick as far as something prime psychoanalysis of fat patients with quintessence 2 diabetes and unassuming to reasonable hyperglycaemia (370). As a replacement for each perseverant the endanger of hypoglycaemia sine qua non be considered when determining the target HbA1c even, markedly in people treated with insulin and those with pattern 1 diabetes. Trim care practitioners should be au fait that more comprehensive glycaemic in check increases the peril of hypo- glycaemia. Manner, it is consequential to declare targets appropriate to the particular and in consultation with him or her. It is also signal to respect that adherence to medicines is much move in real-life settings than in clinical trials. The results of controlled trials are implausible to be achieved in clinical practice unless specific measures are enchanted to update compliance with treatment. Treatment should aim to about: a fasting blood glucose flush of 4 7 mmol/l (72 126 mg/dl); an HbA1c unfluctuating of 6. The first propose to to controlling glycaemia should be because of sustenance unparalleled; if this is not sufficient, viva voce medication should be specified, followed by insulin if compelling. Aspirin psychotherapy Subject Does long-term treatment with aspirin break down cardiovascular risk? The numbers of women enrolled in most of these trials were too undersized to make allowance brawny con- clusions to be drawn about the role of aspirin in principal prevention with a view women. A review of observational studies (380) suggested that the unobtrusive gamble of major gastrointestinal complications is around 1 2 per 1000 per year at length of existence 60 years. The excess risks attributable to aspirin are therefore 1 2 per 1000 per year at era 60. Extent unselected people below 60 years, that being so, the expected benefit in terms of myocardial infarction (2 per 1000 per year avoided) does not overextend the expected gamble of a critical gastrointestinal bleed.
Buy clomiphene canada. Women's Health - Dr. Rachel Lee Bon Secours Hampton Roads.




